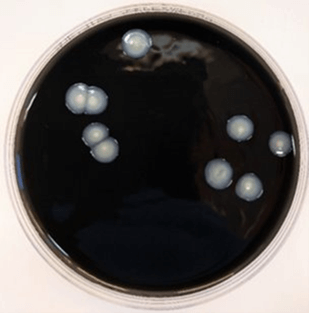
colonies of legionella bacteria

Ellinoora Savonen, University of Oulu, ellinoora.savonen@oulu.fi
Though Legionnaires’ disease is quite a rare infection, it can have life-threatening outcomes. Thus, improving our understanding of the factors affecting the disease incidence as well as the occurrence of its causative agent, Legionella bacteria, in both natural and built aquatic environments is essential.
Drinking water – clean but not sterile
Although drinking water provided by water utilities must meet certain water quality requirements and targets set for it, drinking water has never been considered or required to be sterile. Micro-organisms, including pathogens, can access treated drinking water by breaking through the water treatment process, regrowing from biofilms, or intrusion of non-treated water into the water distribution system (LeChevallier et al., 2024).
When we think of drinking water-related outbreaks, we often consider fecal-oral pathogens, which always have a probability of disease. However, an increasing number of drinking water-related outbreaks are caused by opportunistic pathogens, i.e., microbes that can cause an infectious disease, especially in individuals with a weakened immune system (LeChevallier et al., 2024). Among the most common opportunistic pathogens in drinking water are Legionella bacteria, found in small amounts in natural fresh water and soil. Legionella are mainly transmitted by water aerosols and can cause an infectious disease called legionellosis in humans. (Gattuso et al., 2022; LeChevallier et al., 2024).

Discovery of Legionella and the current state of the art
Legionella bacteria were named after the first recognized epidemic they caused among the attendees of the American Legion convention held in Bellevue-Stratford Hotel, Philadelphia, USA in 1976 (Winn, 1988). Likewise, the most severe form of legionellosis, pneumonia, was named “Legionnaires’ disease” (LD) after the Philadelphia victims. At the time of the incident, the pathogen, named as the “Philadelphia killer” by the press, was unknown to the scientific community. Nowadays, the epidemiology and occurrence of Legionella, especially in built aquatic environments, has been quite extensively studied, thanks to the developed diagnostics and analysis methods.
Yet, some unsolved questions remain. Today, the attention of scientists has been drawn to the rising incidence of LD in Europe and the USA. Along with other possible explanatory factors such as improved diagnostics, aging population, and water infrastructure, the effect of changing climate and weather conditions on LD incidence has been investigated in several countries. Of the most studied meteorological factors, precipitation, air temperature, and relative humidity have had positive associations with the incidence of LD, whereas indications for negative association have been observed for wind speed, pressure, ultraviolet (UV) radiation, sunshine duration, and visibility (Pampaka et al., 2022). However, in the Nordic countries, where the weather conditions differ from the southern regions, especially regarding winter, these types of studies are scarce.

Towards improved understanding
Likewise, research regarding the occurrence of Legionella bacteria in drinking water and domestic hot water has focused particularly on the conditions prevailing within buildings’ water systems.
Yet, more information is needed on how well Legionella are controlled by the raw water treatment process and to what degree they occur in the raw water itself, especially groundwater. My research aims to provide more insight into the factors that affect the incidence and spatiotemporal variation of LD in Nordic weather conditions, as well as the occurrence of Legionella in buildings’ water systems and natural waters. The research will also contribute to environmental surveillance and epidemiologic case studies through the testing of an analysis method able to identify several Legionella species.
References
Gattuso, G., Rizzo, R., Lavoro, A., Spoto, V., Porciello, G., Montagnese, C., Cinà, D., Cosentino, A., Lombardo, C., Mezzatesta, M.L., Salmeri, M., 2022. Overview of the Clinical and Molecular Features of Legionella Pneumophila: Focus on Novel Surveillance and Diagnostic Strategies. Antibiot. 11, 370. https://doi.org/10.3390/ANTIBIOTICS11030370.
LeChevallier, M.W., Prosser, T. & Stevens, M., 2024. Opportunistic Pathogens in Drinking Water Distribution Systems—A Review. Microorg. 12, 916. https://doi.org/10.3390/microorganisms12050916.
Mercante, J.W., Winchell, J.M., 2015. Current and Emerging Legionella Diagnostics for Laboratory and Outbreak Investigations. Clin. Microbiol. Rev. 28, 95–133. https://doi.org/10.1128/CMR.00029-14.
Pampaka, D., Gómez-Barroso, D., López-Perea, N., Carmona, R.C., Portero, R., 2022. Meteorological conditions and Legionnaires’ disease sporadic cases-a systematic review. Environ. Res. 214, 114080. https://doi.org/10.1016/j.envres.2022.114080.
Winn, W.C. 1988. Legionnaires disease: historical perspective. Clin. Microbiol. Rev. 1, 60-81. https://doi.org/10.1128/CMR.1.1.60.
27.11.2025